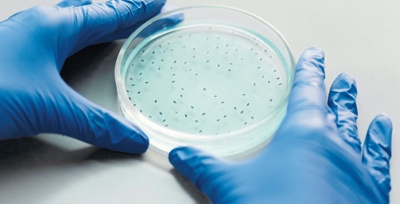

MEDELLÍN, COLOMBIA, SURAMERICA No. 322 JULIO DEL AÑO 2025 ISNN 0124-4388
MEDELLÍN, COLOMBIA, SURAMERICA No. 322 JULIO DEL AÑO 2025 ISNN 0124-4388

Una investigación realizada en conjunto con diferentes entidades, como el Instituto IMDEA Alimentación y la Universidad Internacional de Valencia, comprobó el valor de la quinoa para el sistema inmunológico y la prevención de enfermedades metabólicas. El consumo de este cereal ayuda a contrarrestar los desequilibrios alimentarios que pueden surgir por un exceso de azúcar o grasas, haciéndolo eficaz frente a la resistencia a la insulina y otras enfermedades metabólicas crónicas.

Una investigación publicada en BMJ Nutrition, Prevention and Health expuso los riesgos mentales asociados con una dieta muy baja en calorías. A partir de la Encuesta Nacional de Salud y Nutrición de Estados Unidos, el equipo encontró que quienes seguían una dieta muy estricta, y no necesariamente equilibrada en nutrientes, reportaban mayores síntomas de depresión. Por ello, se plantea la posibilidad de que la ingesta de grasas como el omega-3 también influya en la salud mental.

La Universidad de Míchigan elaboró un estudio para PLOS ONE sobre el potencial adictivo del queso. Este lácteo, especialmente en alimentos procesados, contiene un compuesto llamado caseína, que al descomponerse libera una sustancia que estimula el cerebro a producir una sensación de placer similar a la que generan algunas drogas. Los hallazgos plantean la posibilidad de que la ingesta de ciertos alimentos pueda controlarse como si se tratara de una forma de adicción.

Un estudio publicado en Cell indica los riesgos asociados con los trasplantes de microbiota fecal. Se trata de un procedimiento en el que se extraen microbios de los desechos de un donante sano y se introducen en una zona del intestino del receptor para mejorar su microbiota. El equipo de la Universidad de Chicago mostró que estos organismos, en el cuerpo de ratones, pueden desplazarse a otras partes del sistema intestinal con una microbiota distinta, lo que podría afectar el metabolismo o el gasto de energía.

Un estudio del Instituto Garvan de Investigación Médica y del Instituto Kirby de la Universidad de Nueva Gales del Sur confirmó que el brazo que se elija para recibir la vacunación influye en el proceso de inmunización. Este hallazgo, publicado en la revista Cell, demostró que aplicar todas las dosis en el mismo brazo ayuda a estimular el sistema inmunitario y a producir anticuerpos que reaccionan mejor frente a la infección.

Una investigación publicada en la revista JAMA Neurology sobre el consumo regular de marihuana expone una posible relación con la demencia. Los autores recopilaron información médica de seis millones de personas en la provincia de Ontario, Canadá, que no padecían demencia. Entre quienes fueron hospitalizados por consumo de cannabis, al 5 % se le diagnosticó demencia después de cinco años, y al 19 %, después de diez años. Este fenómeno podría deberse a que el consumo excesivo de marihuana afecta las conexiones neuronales.

Un estudio publicado en Psychological Bulletin, de la Asociación Estadounidense de Psicología, demostró los riesgos de que los niños pasen demasiado tiempo frente a las pantallas. Se analizaron más de cien investigaciones relacionadas con el tema y se concluyó que los niños de muy corta edad que utilizan durante horas dispositivos electrónicos pueden desarrollar dificultades para controlar sus emociones e interactuar con el entorno, lo que los lleva a recurrir con mayor frecuencia a estos aparatos como vía de escape.

Una investigación de diversas instituciones en Estados Unidos ayudó a comprender la diferencia de estatura entre los sexos. El análisis utilizó información de más de 900.000 personas, incluidas 1.225 con cromosomas adicionales o ausentes. El resultado, publicado en Proceedings of the National Academy of Sciences, mostró que tener un cromosoma Y adicional —presente solo en hombres— otorgaba mayor estatura que uno X. Por ello, la diferencia entre ambos cromosomas podría influir en que los hombres sean más altos.

El síndrome de corazón roto ocurre cuando una situación provoca niveles extremos de emoción o estrés, ocasionando un dolor similar al de un ataque cardiaco. Un estudio publicado en Journal of the American Heart Association, que examinó a cerca de 200.000 pacientes con esta condición, encontró que, aunque es más frecuente en mujeres, resulta más letal en hombres. Los autores consideran que los hombres producen más catecolaminas, la hormona responsable del síndrome, lo que hace más crítica la experiencia.

Un estudio reciente de la Universidad de Misuri, EE. UU., publicado en Journal of Applied Physiology, muestra que tras diez días de inactividad física se presentan cambios en el cerebro asociados con el deterioro cognitivo, además de resistencia a la insulina y un aumento en la producción de especies reactivas de oxígeno en el hipocampo, la región cerebral implicada en la memoria y el aprendizaje. El estudio también reveló que la inactividad muscular eleva los niveles de ciertas proteínas en el cerebro, estrechamente asociadas con la enfermedad de Alzheimer.

Un estudio realizado por el Instituto de Investigación Germans Trias i Pujol (IGTP) de Badalona, en colaboración con el Instituto de Salud Global de Barcelona (ISGlobal), identificó una relación entre el gen FOXP4 y la COVID persistente. La investigación, basada en el análisis de datos genéticos de más de un millón de personas, representa un avance significativo en la comprensión de esta condición. Los resultados permitirán diferenciar subtipos de COVID persistente, lo que abre la puerta a una atención médica más personalizada.

Un estudio realizado por neurocientíficos y publicado en la revista Brain Structure and Function reveló que permanecer en silencio durante al menos dos horas al día genera beneficios para la salud mental. El hallazgo se basa en evidencias que vinculan la ausencia de estímulos sonoros con la regeneración neuronal, mejoras cognitivas y estabilidad emocional. Por otro lado, la exposición frecuente al ruido del tráfico, las pantallas o las conversaciones extensas interrumpe los procesos naturales de recuperación del cerebro.
Los organismos presentes en el aire, el suelo y diversas superficies del hogar pueden desempeñar un papel fundamental en la salud, por lo que una desinfección excesiva podría resultar perjudicial. Según expertos, promover la diversidad microbiana en casa sería una mejor opción. Erica M. Hartmann, profesora asociada de la Universidad Northwestern, recomendó limpiar de forma estratégica y concentrarse en áreas específicas, como la cocina y el baño, para prevenir la proliferación de patógenos.

El tabaquismo continúa siendo la principal causa prevenible de enfermedad y muerte en el mundo. Cada año provoca más de ocho millones de fallecimientos, la mayoría de ellos relacionados con el cáncer de pulmón. De acuerdo con la Encuesta sobre Alcohol y Otras Drogas en España (EDADES), realizada por el Ministerio de Sanidad, en el último año el 67,7 % de las personas que fuman a diario ha pensado en dejar el tabaco, y el 44,1 % incluso ha hecho algún intento por dejarlo. Abandonar el hábito permite recuperar los sentidos del gusto y del olfato, que suelen deteriorarse con el consumo habitual de cigarrillo.

La salud humana y el animal están relacionadas, por lo que se requiere un enfoque integral ante las crisis sanitarias. Un informe de la Organización Mundial de Sanidad Animal (OMSA) alerta que los brotes de gripe aviar en mamíferos se duplicaron en 2024, con 1.022 casos en 55 países, frente a los 459 registrados en 2023. El informe destaca que casi la mitad de las enfermedades animales notificadas entre 2005 y 2023, y agrupadas en la lista de la OMSA, representan una amenaza para los seres humanos por su carácter zoonótico.

Una investigación reciente del Programa Gestión del Conocimiento en Contaminación Atmosférica y sus Efectos en la Salud, llevada a cabo mediante una articulación académica interdisciplinaria, destaca que el material particulado PM2.5 del Valle de Aburrá no solo deteriora la calidad del aire, sino que también daña el ADN en humanos, animales, plantas y microorganismos, generando efectos mutagénicos y citogenéticos. Esta complejidad exige decisiones integrales que reconozcan el impacto desigual que tiene la contaminación en los sectores más vulnerables de la población.
Si usted está interesado en alguno de los libros de la Editorial San Vicente Fundación, ingrese al siguiente link, acceda a nuestro catálogo y realice su proceso de compra
Visitar catálogo
Tel: (4) 516 74 43
Cel: 3017547479
diana.arbelaez@sanvicentefundacion.com